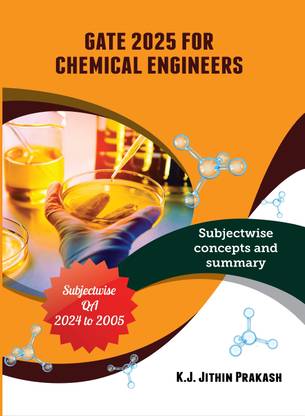
GATE Exam Collection for 2025 -Subjectwise Solved 20 Years of Question Papers and detailed Objective type Answers from 2005 till 2024, Chemical Engineering

GATE Exam Collection for 2025 -Subjectwise Solved 20 Years of Question Papers and detailed Objective type Answers from 2005 till 2024, Chemical Engineering (Paperback, K.J. Jithin Prakash)
Share
GATE Exam Collection for 2025 -Subjectwise Solved 20 Years of Question Papers and detailed Objective type Answers from 2005 till 2024, Chemical Engineering (Paperback, K.J. Jithin Prakash)
Be the first to Review this product
Special price
₹816
₹950
14% off
Available offers
T&C
T&C
T&C
T&C
Delivery
Check
Enter pincode
Delivery by28 Dec, Sunday
?
View Details
Highlights
- Binding: Paperback
- Publisher: BOHR Publishers
- Genre: Engineering
- ISBN: 9788194228585, 978-81-942285-8-5
- Edition: Chemical Engineering, 2024
- Pages: 848
Services
- Cash on Delivery available?
Seller
Description
Gate 2025 For Chemical Engineers is a careful effort that is highly suggested for individuals who want to pass GATE 2025 with high enough scores/ranks to be admitted to master's programmes. K J Jithin Prakash, an IIT Kharagpur alumnus who achieved the 94th rank, wrote the book in response to the difficulties faced by GATE aspirants. The problems from 2005 to 2024 are covered in reverse chronological order, which is an excellent practise for a true GATE candidate. The book takes a complete approach to all of the chapters on the GATE syllabus, from Engineering Mathematics to General Aptitude. It has a unique property in that it not only provides the answer but also the solution. 1. Solved papers from the previous 20 years 2. Designed in accordance with the most recent examination pattern 3. Insights into the type of question 4. The entire curriculum is covered, and the pattern is always changing. Contents Table of Contents Paper that has been solved (2005-2024), Engineering Mathematics, Chemical Process Calculations, Thermodynamics, Fluid Mechanics, Mechanical Operations, Heat Transfer, Mass Transfer, Chemical Reaction Engineering, Instrumentation and Process Control, Plant Design and Economics, Chemical Technology, General Aptitude, Mock Tests with Unit-wise Numerical Answer Type Questions.
Read More
Specifications
| Publication Year |
|
Manufacturing, Packaging and Import Info
Be the first to ask about this product
Safe and Secure Payments.Easy returns.100% Authentic products.
Back to top




